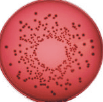

Colony counter

|
Color QCount, automatic colony counter Very easy to use, works right out of the box. Very efficient, it can process up to 400 plates per hour. The lighting assures uniform illumination, enhance colony contrast. It differenciate overlapping colony clusters. ColorCount Software automatically determines the threshold of the background color. It recognizes subtle color variations and can count each hue of one color or a range of shades as one color. Stored data is GLP compliant. Each plate image is saved in a databank and can be reanalysed. Users can manually exclude area, add or delete colonies. Hand counted plates can also be entered in the databank. All edits are tracked with operator's identification, date, time and comments. Technical parameters
|
||||||||||||||||||||||||||||
 |
QCount, automatic colony counter Very easy to use, works right out of the box. Very efficient, it can process up to 400 plates per hour. The lighting assures uniform illumination, enhance colony contrast. It differenciate overlapping colony clusters. ColorCount Software automatically determines the threshold of the background color. Stored data is GLP compliant. Each plate image is saved in a databank and can be reanalysed. Users can manually exclude area , add or delete colonies. Hand counted plates can also be entered in the databank. All edits are tracked with operator's identification, date, time and comments. Technical parameters
|
||||||||||||||||||||||||||||
 |
PetriScan, automatic colony counter For dry film counting. High Throughput: can process 4 films in less than 1 minute. Cost effective: increase productivity, reduce errors, the personnel has freeing time for other responsibilities. PetriScan Software automatically determines the threshold of the background color by using gray scale analysis. Stored data is GLP compliant. Each film image is saved in a databank and can be reanalysed. Users can add or delete colonies. All edits are tracked with operator's identification, date, time and comments. Technical parameters
|
||||||||||||||||||||||||||||

|
Plating System Autoplate For spiral plating. Advantages:
A syringe-driven dispensing stylus deposits sample onto a rotating agar plate. The stylus moves from the near-center outward while the plate rotates as the syringe drives downward, depositing less sample as the stylus moves outward. This unique plating action eliminates most serial dilutions by continuously reducing the number of microbes placed along the spiral track.
|
||||||||||||||||||||||||||||
 |
Solid Sample Preparation for Microbiology, BagSystem The BagMixer® is a solid sample preparation system which blends the sample materials with a stomach-like action in a sterile bag. The bag is repetitively squeezed to break up the contents. Special filter bags automatically separate the juice or inoculum from the solids. A range of accessories facilitate bag handling and storage. Advantages:
|
||||||||||||||||||||||||||||
 |
Gravimetric Diluter Lab Pro The LabPro accurately and reliably automates preparation of samples. It can be used to dilute random-weight samples gravimetrically, as well as dispense liquids in predefined volumes. A LabPro pump is interfaced with a stand-alone, Explorer balance. The controller calculates the amount of diluent to be dispensed in the sample container, based on the sample weight and userdefined diluent/sample weight ratio. For example, a weight ratio of 9.00 applied to a sample weight of 11.0. grams will result in dispensing 99.0 grams of diluent, to produce a 1:10 dilution of the sample.
|
||||||||||||||||||||||||||||
 |
Manual Colony counter Schuett Count
Technical Data
|
Oberdorfstrasse 51
CH 3930 Eyholz
tel + 41 27 946 80 18
fax + 41 27 946 86 42
info@sysmatec.ch